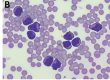
Laboklin: eine stark erhöhte Serum-Amyloid-A-Konzentration (850,15 μg/ml) und einen Serum-Thymidinkinase-Wert von 19,3 U/l (Referenzbereich < 3 U/l).

Vor oder zu Beginn der Zuchtsaison wird besonderes Augenmerk auf die Stuten gerichtet, die im vergangenen Jahr nicht aufgenommen oder verfohlt haben. Die Endometritis stellt in diesem Zusammenhang neben der Endometrose die am häufigsten diagnostizierte Gynäkopathie der Pferdestute dar, sodass der umfassenden Abklärung ihrer Ursachen eine besondere Bedeutung zukommt.
Leukozyteninfiltrate in der Uterusschleimhaut stellen allerdings nicht per se einen pathologischen Befund dar; so kommt es z.B. nach der Belegung/Besamung regelmäßig zu einer transienten Entzündungsreaktion, die innerhalb von 24 – 48 Stunden post inseminationem wieder abgeklungen ist.
Als Endometritis werden daher alle Entzündungsprozesse bezeichnet, die über die physiologische Selbstreinigung des Endometriums hinausgehen, unabhängig von ihrer Ätiologie. Das Allgemeinbefinden der Stuten ist dabei in den meisten Fällen ungestört.
Die Entzündungsreaktionen können nach unterschiedlichen Gesichtspunkten eingeteilt werden:
1. Klinisches Erscheinungsbild
1.1. Akute katarrhalische Endometritiden gehen mit einer graduell variablen Flüssigkeitsbildung einher, die klinisch mittels rektaler Palpation des Uterus, sonografischer Untersuchung oder durch die grobsinnliche und/oder zytologische Untersuchung von Vaginalausfluss nachgewiesen werden kann.
1.2. Die chronische lymphoplasmazellulär dominierte Endometritis (Endometritis sicca) entzieht sich der klinischen Diagnostik, da sie keine Exsudation von Entzündungszellen in das Uteruslumen hinein erzeugt. Weiterhin verläuft die bakteriologische Untersuchung häufig mit negativem Ergebnis, da es sich ursächlich um eine chronische lokale immunologische Dysregulation zu handeln scheint. Der Goldstandard für die umfassende Diagnose einer Endometritis sicca ist damit die histologische Untersuchung eines Endometriumbioptats (s.u.).
2. Ätiologie
2.1. Zu den infektiösen Endometritiden zählen die venerischen Infektionen, wie z.B. die Beschälseuche der Pferde, hervorgerufen durch Trypanosoma equiperdum, die jedoch aktuell in Mitteleuropa als getilgt gilt.
Die kontagiöse equine Metritis (CEM) wird durch das Bakterium Taylorella equigenitalis verursacht und ist eine meldepflichtige Erkrankung. Der Nachweis erfolgt entweder kulturell oder mittels PCR. Darüber hinaus können aber auch verschiedene andere Bakteriengattungen an der Entstehung oder der Aufrechterhaltung einer Endometritis beteiligt sein.
- Abb. 1: Mittels einer Uterusbiopsiezange (oben links) werden Proben des Endometriums mit einem Durchmesser von ca. 0,5 cm gewonnen (oben rechts) und sofort nach der Entnahme in 10 %igem gepuffertem Formalin fixiert (unten links). Nach der Aufarbeitung der Proben im Labor ist eine histologische Charakterisierung der Entzündungsprozesse möglich (unten rechts).
- Abb. 2: Chronische follikuläre (F) lymphoplas-mazelluläre Endometritis ohne Exsudatbildung (HE-Färbung, 200x)
- Abb. 3: Schematische Darstellung einer Verbesserung der Fertilitätsprognose nach erfolgreicher Therapie einer Endometritis unter Berücksichtigung klinisch-gynäkologischer Befunde. Hierbei ist histologisch in Kategorie III eine hochgradige Entzündung, in Kategorie I hingegen eine geringe oder klinisch nicht mehr relevante Leukozyteninfiltration des Endometriums nachweisbar.
Aus 6291 Uterustupfern, die Laboklin im Jahr 2019 zur bakteriologischen Untersuchung eingesandt wurden, konnten in ca. 26 % der Proben pathogene Keime nachgewiesen werden. Hierbei handelte es sich zum größten Teil (84 %) um ß-hämolysierende Streptokokken, seltener konnten Klebsiella sp. (5,5 %), E. coli var. haemolytica (5,19 %), Staph. aureus (2,63 %) oder Pseudomonas aeruginosa (2,15 %) nachgewiesen werden.
Insbesondere Pseudomonaden und E. coli besitzen die Fähigkeit zur Bildung von Biofilmen im Uterus, woraus ein vermindertes Ansprechen auf eine Antibiotikatherapie resultieren kann.
Seltener sind Pilzinfektionen die Ursache einer Endometritis, allerdings sollte z.B. nach einer lang andauernden Antibiotikatherapie auch die mykologische Untersuchung eines Uterustupfers angefordert werden. Die größte Rolle in diesem Zusammenhang spielen Hefen der Gattung Candida, seltener werden Schimmelpilze wie Aspergillus sp. nachgewiesen.
2.2. Prädisponierend für das Auftreten einer nicht-infektiösen Endometritis sind anatomische Veränderungen des äußeren Genitales, z.B. ein mangelhafter Schamschluss, Vernarbungen nach Schwergeburten, ein nach kranial eingesunkener Anus infolge eines reduzierten Körperfettanteils etc., die das Eindringen von Luft oder Urin in die Vagina oder sogar den Uterus begünstigen.
Die häufigste Ursache einer nicht-infektiösen Endometritis ist allerdings eine Belegung/ Besamung, die eine entzündliche Reaktion des Endometriums hervorruft (belegungsinduzierte Endometritis). Physiologischerweise handelt es sich um eine transiente Entzündung, die nach 48 Stunden dank einer effektiven uterinen Clearance abgeklungen ist.
Bei einigen Stuten liegt jedoch eine erhöhte Empfänglichkeit für die Entwicklung einer persistierenden belegungsinduzierten Endometritis vor (sog. „susceptible mares“), sodass es nach dem Kontakt des Endometriums mit dem Sperma zu einer Entzündung mit massiver Flüssigkeitsakkumulation kommt, die nicht aus dem Uterus abtransportiert werden kann. Somit entwickelt sich eine persistierende Endometritis, die zu dem Verlust der Fruchtanlage führt.
3. Labordiagnostik
Bakteriologische, zytologische und molekulargenetische Untersuchungen:
Werden im Rahmen der speziellen klinisch-gynäkologischen Untersuchung vaginaler Ausfluss oder Sekretspuren im Bereich des äußeren Genitale nachgewiesen, die auf eine exsudative Entzündung im Genitaltrakt hinweisen, empfiehlt sich die Entnahme eines sterilen Uterusabstrichs und die Untersuchung von zytologischen Proben.
Die Entnahme eines sterilen Uterustupfers für die bakteriologische Untersuchung erfolgt optimalerweise instrumentell mittels Spekulum, Zervixfasszange und Tupferentnahmesystemen, da bei dieser Methode die Gefahr einer Kontamination durch die bakterielle Flora der Vagina oder des äußeren Genitale am geringsten ist. Weiterhin wird auf diese Weise eine hohe Aussagekraft der bakteriologischen Untersuchung gewährleistet. Unmittelbar nach der Entnahme sollte der Tupfer in ein Transportmedium (Amies-Medium) überführt und beschriftet werden, um Verwechslungen zu vermeiden. Ein Transport sollte gekühlt über Nacht in das Labor erfolgen. Anschließend an die Entnahme des Uterustupfers ist eine Beprobung des Endometriums für eine zytologische (und ggf. histologische) Untersuchung sinnvoll.
Für den Nachweis von Taylorella equigenitalis ist kein Abstrich aus dem Uterus, sondern ein Doppeltupfer (in Amies-Medium mit Aktivkohlezusatz) aus der Fossa clitoridis und dem Sinus clitoridis zu entnehmen (laut Richtlinie 92/65/EWG).
Die unverzügliche Einsendung des Tupfers nach der Beprobung ist immer zu bevorzugen; grundsätzlich sollten bis zum Beginn der bakteriologischen Untersuchung nicht mehr als 24 und für einen PCR-Test nicht mehr als 48 Stunden vergehen. Bei der Kombination beider Methoden ist zu beachten, dass für den PCR-Test und die kulturelle Untersuchung jeweils ein separater Tupfer eingesandt werden muss.
Die Zytologie gibt Aufschluss über den Charakter des Sekrets. Vorteil dieser Methode ist, dass sie schnell, einfach und nicht-invasiv durchzuführen ist. Mit einem doppelt geschützten Entnahmesystem und einer Zytologiebürste werden Sekret und Zellen von der Oberfläche des Endometriums aufgenommen und auf einem Objektträger ausgerollt, der luftgetrocknet und im Labor mittels Diff-Quik-Färbung mikroskopisch beurteilt wird. Das Vorhandensein von großen Schleimmengen im Ausstrich kann das Vorliegen einer Mukometra anzeigen. Der Nachweis neutrophiler Granulozyten sowie eventuell auch von Bakterien oder Pilzen spricht für eine eitrige Entzündung und demzufolge für eine Infektion.
Vorteil der Kombination einer bakteriologischen und zytologischen Untersuchung ist eine deutlich erhöhte diagnostische Sensitivität sowie die Einschätzung falsch-negativer bakteriologischer Ergebnisse (z.B. infolge einer nicht repräsentativen Probenentnahme).
Die bis hierher dargestellten Untersuchungsmethoden sind geeignet, eine katarrhalisch-eitrige Endometritis zu identifizieren, da es sich um nicht-invasive Probenentnahmetechniken handelt.
Im Gegensatz dazu können Entzündungsprozesse, die nicht mit einer Exsudation von Leukozyten in das Uteruslumen hinein verbunden sind, klinisch, bakteriologisch und zytologisch nicht diagnostiziert werden.
Endometriumbioptate (Histologie)
Die Methode der Wahl für eine umfassende Aussage über chronische und/oder tief im Endometrium lokalisierte Entzündungsprozesse ist die histopathologische Untersuchung von Uterusbioptaten. Daher ist die Biopsie bei güsten Stuten zu Beginn der Saison in Kombination mit einer bakteriologischen Untersuchung empfehlenswert.
Die Entnahme der Gewebeproben aus dem Endometrium erfolgt vaginal mittels Biopsiezange. Die Probe der Gebärmutterschleimhaut wird sofort in 10 %iges gepuffertes Formalin überführt (Abb. 1). Auch wenn es sich um eine (gering) invasive Methode handelt, zeigen die Stuten in den meisten Fällen keine Reaktion auf die Entnahme, da die Uterusschleimhaut zu den Geweben mit hoher Regenerationskapazität zählt.
Im Rahmen der histopathologischen Untersuchung der Bioptate werden Grad, Charakter, Lokalisation, Ausdehnung und zeitlicher Verlauf der Entzündungsreaktion erfasst. Dies dient erstens einer gerichteten Ermittlung der Ursache (z.B. eitrige Entzündung – bakteriell/Pilze; eosinophile Entzündung – Spermaverdünner, Spülung, Fremdkörper; lymphoplasmazelluläre Entzündung – chronische lokale Immunreaktion), weiterhin sind die Kriterien für eine epikritische Beurteilung der Läsionen hinsichtlich des Erfolgs einer Therapie und letztendlich der Fertilitätsprognose relevant.
Die Fertilitätsprognose nach Kenney & Doig (1986) und nach Schoon et al. (1992 und 1997):
Entzündliche Läsionen des Endometriums fließen in die Kategorisierung nach Kenney & Doig (1986) mit ein, wobei allerdings die Klinik der entzündlichen Alteration, ihr histopathologischer Charakter und auch ihre Reversibilität nicht berücksichtigt werden. Da diese Faktoren aber eine wesentliche Rolle für eine umfassende Interpretation spielen, wird hierauf in der epikritischen Einschätzung der Ergebnisse näher eingegangen (Schoon et al. 1992 und 1997) (s. Abb. 2).
Die Kategorien nach Kenney & Doig 1986 sind mit der statistischen Wahrscheinlichkeit korreliert, dass die Stute konzipiert und das Fohlen erfolgreich austrägt (s. Tab. 1).
Tab. 1: Kategorisierung basierend auf histopathologischen Befunden am Endometrium nach Kenney und Doig (1986)
Kategorie Abfohlwahrscheinlichkeit
I 80 – 90 %
IIa 50 – 80 %
IIb 10 – 50 %
III < 10 %
Die Kategorisierung stellt eine zum jeweiligen Zeitpunkt aktuelle Einschätzung des zu erwartenden Zuchterfolges dar; wichtig ist jedoch, dass abhängig von der Art der Endometritis und dem Erfolg einer Therapie eine Verbesserung der Kategorie erfolgen kann (s. Abb. 3).
Bei der epikritischen Beurteilung der histopathologischen Befunde werden daher z.B. auch das Alter der Stute, die Güstzeit, die Lokalisation der Endometritis und ihr Charakter mit einbezogen, um eine Einschätzungshilfe für die praktisch tätigen Kolleg*innen zu liefern, ob eine gezielte Therapie Aussicht auf Erfolg haben kann oder nicht.
Dr. Kathrin Jäger